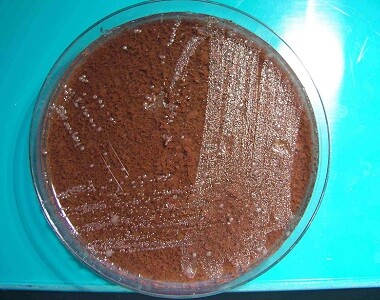

Těhotenství
Zvolte si týden těhotenství, který potřebujete, a přečtěte si podrobné informace Vašeho těhotenství týden po týdnu.
Co vás zajímá

5. týden těhotenství
Kalkulačky:
Ovulační kalkulačka
Vypočtěte si váš termín ovulace!
Kdy budete mít plodné dny?
Výpočet ovulace vám provede naše ovulační kalkulačka.
Těhotenská kalkulačka
Vypočtěte si v naší těhotenské kalkulačce, kdy vás čekají ultrazvuky, kdy obdržíte těhotenskou průkazku, kdy se podrobíte triple testu, kdy se vyšetřuje streptokok, kdy se provádí amniocentéza, kdy byste si měla nachystat věci do porodnice, kdy nastupujete mateřskou dovolenou.
Termíny očkování
Kdy bude vaše dítě očkováno proti nemocem zahrnutým v rámci pravidelného očkovacího kalendáře?
BMI
Kategorie BMI jsou zjednodušeným modelem, které nám pomáhají se zorientovat v naší tělesné hmotnosti. Body Mass Index (BMI) udává méně přesné údaje zejména u dětí, starších lidí a aktivních sportovců. Přesnější posouzení tělesné váhy než kalkulačka BMI může provést odborník, který zahrne i další parametry: např. pohlaví, věk, objem svalů, typ postavy a celkový životní styl.
O těhotenství, trimestry těhotenství, změny v těle ženy, vývoj plodu, péče o ženu v těhotenství, vyšetření – screening a komplikace
Co je těhotenství?
Těhotenství je období života ženy, kdy se v jejím těle po dobu 9 měsíců vyvíjí plod.
Jak se těhotenství počítá?
Těhotenství trvá přesně 40 týdnů, 10 lunárních měsíců. Počítá se od prvního dne poslední menstruace, i když žena otěhotní až zhruba 2 týdny poté – viz Délka těhotenství
Fáze těhotenství
Těhotenství dělíme na tři stejně dlouhé úseky – trimestry. U miminka pak rozlišujeme do 9. týdne včetně embryo-zárodek a následně fetus-plod.
Otěhotnění
Žena by měla svůj životní styl upravit již v době plánování těhotenství.
Je dobré vědět, jak otěhotnět, kdy je možnost otěhotnění nejpravděpodobnější. Že oplození ještě neznamená otěhotnění. Jestli můžete ovlivnit pohlaví miminka a jak poznáte, že jste těhotná, jaké jsou příznaky těhotenství. Jak si správně provést těhotenský test. Jak vypočítat termín porodu, nejen podle prvního dne poslední menstruace, ale také podle data oplozující soulože, znáte-li je.
První trimestr (0. až 13. týden těhotenství)
V prvních týdnech má zárodek rysy shodné se zárodky zvířat, zhruba ve 12. týdnu těhotenství se začíná podobat lidské bytosti. Kolem 8. týdne jsou rozeznatelné oči, uši, nos a ústa. Také vytvořeny prsty. První trimestr je nejdůležitější stran možného poškození plodu nejrůznějšími vnějšími vlivy.

Zárodek klokan (ZOO Chleby) vs. lidský zárodek
Druhý trimestr (14. týden těhotenství až 27. týden těhotenství)
Nejvýznamnějším v tomto období jsou pohyby plodu, které matka začne cítit kolem 20. týdne těhotenství, druho a vícerodička již kolem 18. týdne těhotenství. Jedná se o období rychlého růstu plodu a vývoje orgánů. Komplikace jako nevolnost začínají ustupovat, naopak se objevují ty, které souvisí se zvětšující se velikostí plodu.
Třetí trimestr (28. týden těhotenství až 40. a více týden těhotenství)
Jedná se o období rychlého zvětšení hmotnosti plodu ze zhruba 1000 na 3200 g. Z těla plodu postupně mizí ochlupení-lanugo, zvětšují se tukové zásoby, svalová hmota a kůže je hladká, růžová, probíhá růst vlasů.
Vývoji miminka se věnujeme nejen v každém týdnu těhotenství, ale podrobně pak v oddíle vývoj miminka týden po týdnu.
Zdravotní péče, prohlídky a vyšetření v těhotenství
Zhruba nejpozději do konce prvního trimestru žena obdrží těhotenskou průkazku. Jedná se o nejdůležitější dokument v těhotenství, který by žena měla mít stále u sebe. Do schématu jednotlivých návštěv v těhotenské poradně, která mají v počátku interval 4-6 týdnů, jsou zahrnuta i tři ultrazvuková vyšetření. První v 11. až 13. týdnu těhotenství, sloužící k určení termínu porodu dle velikosti plodu, ale i vývojových vad plodu. Druhé ve 20. až 22. týdnu těhotenství, které je zaměřeno na velikost plodu, určení množství plodové vody, uložení placenty, pohybů plodu a také vývojových vad. Obdobně pak třetí ultrazvuk mezi 30. až 32. týdnem těhotenství.
Do konce 14. týdne těhotenství se všem těhotným měří hladina cukru na lačno a mezi 24. a 28. týdnem těhotenství podstupují zátěžový test na cukrovku (oGTT – orální glukózový toleranční test).
V posledním trimestru je vhodné se začít seznamovat s problematikou porodu, i s předporodní přípravou.
V oddíle Porodnice v ČR se můžete seznámit s péčí v jednotlivých porodnicích, včetně kurzů předporodní přípravy, jak se v porodnici rodí, jak je to s doprovodem a dalšími záležitostmi.
Pokud nechcete chodit na kurzy v porodnici nebo mimo, tak se určitě běžte seznámit s prostředím porodního sálu, abyste šla s doprovodem již do známého prostředí.
Nezapomeňte si nachystat věci do porodnice a pro miminko doma.
Sama jsem tápala v sociálně-právních záležitostech týkajících se mateřství. Proto i z nich vám přinášíme byť stručné, ale důležité informace. Dozvíte se, co je mateřská a co rodičovská dovolená, jaká výše dávek se vyplácí, co je porodné a kde a jak o dávky žádat.
Změny v těle matky během těhotenství
Mateřský organizmus se během těhotenství mění, musí se přizpůsobit tomu, že plod zasahuje téměř do všech jeho funkcí. Změny se projeví v následujícím:
- Zvýšení tělesné hmotnosti matky v důsledku hmotnosti plodu, placenty, ale i zadržování tekutin. K největšímu nárůstku dochází v posledním trimestru.
- Zvětšující se děloha a změny rodidel.
- Zvětšující se objem krve, počet bílých krvinek a další změny v krevním oběhu. Stoupá také srdeční frekvence a důsledkem tlaku dělohy může docházet k otokům dolních končetin koncem těhotenství.
- Dýchání může ztížit tlak plodu.
- U trávicího traktu je počátkem těhotenství popisována mnoha těhotnými nevolnost, která ustupuje na konci prvního trimestru. V pozdních týdnech těhotenství důsledkem tlaku dělohy na žaludek a uvolněním svěrače jícnu může docházet k pálení žáhy. Hormonální změny vedou k zácpě a také se mění chuť k jídlu.
- Rozšíření močovodů a snížení jejich pohyblivosti může vést k častějším infekcím. Ke konci těhotenství tlak hlavičky snižuje kapacitu močového měchýře a močení je častější.
- Prsa se zvětšují a bradavky mohou pigmentovat a více se prokrvit.
- Na kůži se mohou objevit žlutohnědé skvrny, nejčastěji na břiše jako střední čára. Vlivem hormonů a napínáním kůže se v ní tvoří praskliny-strie.
- V důsledku rozvolnění vazivových spojů v pánvi je častá „kachní“ chůze u těhotných. Může být doprovázena i bolestivostí.
- V těhotenství se změny týkají i psychiky. Budoucí maminky mohou trpět zvýšenou nervozitou, neadekvátními reakcemi na stres a přecitlivělostí. Také poruchami spánku, plačtivostí a depresemi či zvýšenou agresivitou.
Komplikace v těhotenství
I když je těhotenství považováno za fyziologický jev, ne nemoc, tak v jeho průběhu může dojít k patologickým stavům, ohrožujícím matku, dítě nebo obojí. Zásah zdravotníků se odvíjí od stupně komplikace.
Škála je od běžných těhotenských potíží, jako jsou nevolnosti, varixy, zácpa, bolesti, hemoroidy nebo tuhnutí břicha přes infekční onemocnění, inkompatibilitu v Rh faktoru, těhotenskou cukrovku, až po molu, preeklampsii, potrat nebo předčasný porod. O všech je pojednáno v oddíle Komplikace v těhotenství.
Jak si těhotenství užít?
„Těhotenství, zvláště to první, bylo jedním z nejkrásnějších období mého života,“ svěřuje se zakladatelka Babyonline, lékařka Jana Martincová. „Psal se přesně rok 2000, kdy byla porodnost ještě nízká, byla jsem na pracovišti jediná těhotná, všichni se ke mně chovali velmi pěkně, pozorně a ohleduplně, stejně tak manžel doma, a musím přiznat, že jsem si těhotenství velmi užila. Jestli bych něco maminkám doporučila, tak hlavně mít stále zaměstnanou hlavu, aby příliš nemyslely na možné komplikace, dělaly vše pro zdraví sebe i miminka, tedy zdravě žily, včetně pohybu i zdravé výživy, a budovaly si kolem sebe pouze pozitivní, optimizmem naplněné vztahy.“
Zajímavé články z oddílu Těhotenství
- Všechny články
- Nejčtenější články
- Nejnovější články

Brožura 20x o těhotenství
Oblíbená brožura 20x o těhotenství zahrnuje nejčastější otázky těhotných žen s odpověďmi. Nechybí ani prohlídky a vyšetření v těhotenství, příprava vě...

E-book 20x o těhotenství ZDARMA
Stáhněte si NOVĚ 20x o těhotenství jako e-book ZDARMANovinka pro těhotné – rozsáhlá, ale jednoduše vypadající e-kniha s odkazy na všechny důležité inf...

Nejoblíbenější jména roku 2024: Jakub a Eliška opět vedou!
Jaká jména rodiče volili pro své děti v roce 2024 nejčastěji? Která jména si udržela svou oblíbenost, která se propadla a která naopak zaznamenala výr...

Péče o zuby (nejen) v těhotenství
Je pravda, že každé těhotenství připraví nastávající maminku alespoň o jeden zub? Proč se u některých žen během těhotenství zvýší kazivost? Co mohu pr...

Těhotenství a zubní kaz
„U každého dítěte jsem v těhotenství přišla o jeden zub,“ slýchávám často v ordinaci. Jak spolu těhotenství a zvýšené riziko zubního kazu mohou souvis...

Ošetření zubů v těhotenství – co lze a co odložit po porodu?
Jak správně v těhotenství sedět v zubařském křesle? Mohou mi v těhotenství rentgenovat zuby? Jak je to s jejich bělením?

Těhotenství a krvácení (zánět) dásní
Trpíte v těhotenství krvácením dásní? Co se s tím dá dělat? Může mít zánět dásní negativní vliv na zdraví miminka?

Alkohol vs. kvalita spermatu, spermií, vajíček, co obsahuje sperma?
Může mít otěhotnění po konzumaci alkoholu vliv na kvalitu právě uvolněného vajíčka nebo kvalitu spermií ve spermatu? Co všechno obsahuje sperma? Může...

Chlapec nebo holčička?
Je možné cíleně s porodníkem pracovat na výběru pohlaví? Jsou nějaké rozdíly mezi spermiemi X a Y? Je možná u mužů absence jednoho typu spermií?

Jak je to u sportovců? Souložit nebo ne před závodem?
Měli nebo neměli by sportovci před závodem souložit? Souvisí nějak hladina testosteronu s četností pohlavních styků? A následně k tomu hladina testost...

Jak lépe dostat spermie k vajíčku? Ležet? Zvedat nohy? Nevyplachovat?
Jsou nějaké výjimky, kdy se spermie k vajíčku nedostane a je pak u nich možné „přesun“ nějak podpořit? Jak? Může spermie odstranit výplach? Mohou sper...

Jaká je nejlepší poloha pro milování?
Je nějaký rozdíl v polohách a umístění spermatu po ejakulaci? Opravdu má doslova sperma vystříknuté kdekoliv v pochvě stejnou šanci dovézt spermie k v...

Kdy může dojít k početí? Máme mít styk přesně při zvýšení teploty?
Jaké jsou nejdůležitější momenty pro zdárné oplození? Má měření bazální teploty smysl pro načasování oplozujícího pohlavního styku?

Má frekvence pohlavních styků vliv na úspěšnost početí?
Proč má vyšší frekvence pohlavních styků opačný efekt na početí? Proč se doporučuje několikadenní abstinence? Proč je u oplození důležitá kvalita sper...

Může vzrušení ženy nebo orgasmus ovlivnit početí?
Má vzrušení ženy nebo orgasmus vliv na transport spermií k vajíčku? Na čem záleží?

Období vývoje miminka
Na počátku je oplozené vajíčko. Jakými fázemi probíhá vývoj vašeho miminka? Jak se určuje délka těhotenství?

Vajíčko a spermie
Začátek nového života spočívá ve splynutí dvou velmi různých pohlavních buněk - ženské a mužské.

Oplození
Průběh oplození – průnik spermie do vajíčka, stadium ženského a mužského prvojádra a buněčné dělení.

1. týden vývoje miminka
Vajíčko se opakovaně dělí. Nejprve na dvě úplně stejné buňky (blastomery). Při dalším dělení – rýhování – se zárodek podobá plodu moruše (stadium moru...

Fota z IVF
Umělé oplození a časný vývoj mimo mateřský organizmus („ve zkumavce“)

2. týden vývoje miminka
Délka miminka je 0,2 mm. Mateřská krev omývá výběžky zárodku a zajišťuje jejich výživu a přísun kyslíku. Okysličenou krev přivádějí děložní tepny, odk...

3. týden vývoje miminka
Ve třetím týdnu začíná embryonální (zárodečné) období vývoje. Tvoří se zárodečné listy ectoderm, entoderm a mezoderm. Z nich vznikají všechny tělní tk...

4. týden vývoje miminka
Délka zárodku se pohybuje na konci čtvrtého týdne od oplození mezi 6 – 8 mm. Těhotenství je patrné při vyšetření ultrazvukem. Zevní vzhled zárodku se...

5. týden vývoje miminka
Na konci čtvrtého a v pátém týdnu gravidity vyplňuje zárodek spolu se svými obaly jenom malou část děložní dutiny. Zárodek se volně vznáší v plodové v...

6. týden vývoje miminka
Velká mozková část hlavy je stále ještě silně ohnutá dopředu, obličejová část se dotýká srdečního hrbolu. Horní část obličeje tvoří párové výběžky pro...

7. týden vývoje miminka
Hlavová část zárodku je ve srovnání s trupem značně veliká. V obličeji se postupně dokončuje srůst jednotlivých výběžků, které tvořily jeho základ. Na...

8. týden vývoje miminka
Hlava zárodku představuje asi polovinu celkové délky těla. Začíná se zakulacovat a vzpřimovat, takže obličej je zepředu dobře vidět. Tělo zárodku se n...

9.-10. týden vývoje miminka
9. týdnem nastupuje fetální období, které je charakterizováno rychlým růstem těla do délky, zvětšováním a pozvolným vyzráváním vnitřních orgánů. Mění...

11.-12. týden vývoje miminka
Délka plodu obnáší na konci 12. týdne asi 9 cm. Hmotnost plodu se pohybuje se kolem 40 g. V amniovém vaku je v tomto období asi 30 ml plodové (amniové...

13.-16. týden vývoje miminka
Ve 4. lunárním měsíci pokračuje rychlý růst tělíčka plodu do délky. Mozek pokračuje ve svém vývoji. Na povrchu hlavičky začíná být patrný rozsah části...

17.-20. týden vývoje miminka
Délka plodu je již asi 25 cm, hmotnost asi 300 g. Na konci 20. týdne dosáhne plod přibližně polovinu své budoucí porodní délky. Plod může pohybovat rt...

21.-25. týden vývoje miminka
Délka plodu dosahuje asi 30 cm. Hmotnost plodu je kolem 600 – 700 gramů. Těhotenství budoucí maminky je už na první pohled zřejmé. Žena začíná vnímat...

26.-29. týden vývoje miminka
Délka plodu se pohybuje kolem 37 cm, hmotnost dosahuje již v průměru 1230 g. Těhotenstvím zvětšená děloha sahá asi 3 – 4 prsty nad pupek. Plod je veli...

30.-34. týden vývoje miminka
Zdravý plod má na konci 34. týdne obvykle délku asi 45 cm. Hmotnost se pohybuje nečastěji v rozmezí 2 200 až 2 500 g. Horní pól dělohy dosahuje na kon...

35.-38. týden vývoje miminka
Za tento jediný měsíc vzroste hmotnost zpravidla o téměř celou jednu třetinu hodnoty, které plod dosáhl za celých předchozích 34 týdnů nitroděložního...

Jak probíhá porod?
Porod je soubor fyziologických procesů, při nichž jsou plod a jeho obaly spolu s placentou vypuzeny z mateřského organizmu. První impulz k vyvolání po...

Prenatální genetická diagnostika – zjištění nemoci u plodu
Co je to prenatální genetická diagnostika a k čemu slouží? Kdy se provádí invazivní prenatální vyšetření a v čem spočívá?

Preimplantační genetická diagnostika – zjištění nemoci u embrya po umělém oplodnění, před přenosem do dělohy matky
Co to je a kdy se provádí preimplantační genetická diagnostika Jak probíhá genetické vyšetření zárodku? Je možné vadu zjistit a do dělohy přenést pouz...

Proč jít na genetiku, když se nedaří otěhotnět nebo donosit těhotenství
Poruchy plodnosti – neplodnost nebo opakované samovolné potraty - mohou mít řadu příčin, někdy to mohou být i faktory genetické. Kdy jít na genetiku?

Vyšetření otcovství, mateřství, příbuznosti
Z čeho se dnes provádí analýza DNA? Musí k tomu být pouze krev? Co se s tímto biologickým materiálem děje dále? Kdy je otec otcem? Jaká je jistota tes...
Kapavka
Nejčastějším místem infekce je děložní čípek a močová trubice. Hlavními příznaky jsou hnisavý výtok, bodavé bolesti či pálení při močení, i když v 80...

Hepatitida B, C
Je to infekční zánětlivé onemocnění jater. Přenáší se pohlavním stykem a krví.

HIV (AIDS)
Tuto infekci způsobuje virus HIV, který napadá buňky imunitního systému a způsobuje těžkou poruchu imunity. Přenáší se krví a při pohlavním styku.

Kvasinková infekce
Projevuje se zarudnutím zevního genitálu a pochvy s bílým tvarohovitým výtokem a výrazným svěděním. Lékař potvrdí diagnózu na základě kultivačního vyš...

Aminokolpitida (zánět pochvy)
Je to zánětlivé bakteriální onemocnění pochvy. Projevuje se vodnatým výtokem a výrazným rybím zápachem. Hlavním příznakem je nepříjemný pocit pacientk...

Zavšivení
Přenos se děje přímým kontaktem s nemocným člověkem či sdílením malého prostoru s nemocným. Samičky vši kladou vajíčka na chlupy v oblasti ohanbí. Vši...

Svrab
Projevuje se vyrážkou, které předchází intenzivní svědění kůže zvýrazňující se při zahřátí těla (teplá sprcha). Nejčastěji je vidět vyrážka v oblasti...
Trichomoniáza
Projevuje se hnisavým výtokem, svěděním či pálením rodidel, pálením při močení nebo i bolestí při pohlavním styku.

Papilomavirová infekce (HPV- Human papilloma virus)
Projevuje se vznikem genitálních bradavic na stydkých pyscích, v pochvě, na děložním čípku či kolem konečníku.

Genitální herpes
Jedná se o virové onemocnění, které se projevuje vznikem bolestivých puchýřků na zevním genitále, v pochvě, na děložním čípku.

Měkký vřed (Ulcus molle)
Projevuje se vředem na poštěváčku nebo stydkých pyscích. Diagnóza je obtížná, protože se vřed neliší od sekundárně zaníceného genitálního herpesu.

Lymphogranuloma inguinale
Na začátku se projevuje vznikem vřídku na zevním genitálu a děložním čípku. Bývá přítomný hnisavý výtok.

Chlamydiová infekce
Chlamydie jsou nejčastější sexuálně přenosní původci ve vyspělých zemích.

Syfilis - příjice
Jedná se o dlouhodobé (chronické) onemocnění, které postihuje kůži, sliznice a vnitřní orgány.

Ureaplazmata a mykoplazmata
Ureaplazmata jsou běžnou součástí genitální flory žen i mužů. Nacházejí se u 80 % sexuálně aktivních lidí. Mykoplazmata jsou pohlavně přenosné bakteri...

Termín dle poslední menstruace
Vypočtěte si termín porodu podle poslední menstruace

Termín dle data soulože
Vypočtěte si termín porodu podle data soulože!

Co hradí pojišťovna a v jakém věku
Jaké metody a techniky proplácí zdravotní pojišťovna a které budete hradit sami? Je léčba neplodnosti omezena věkem?
Obsah článku
- Co je těhotenství?
- Jak se těhotenství počítá?
- Fáze těhotenství
- Otěhotnění
- První trimestr (0. až 13. týden těhotenství)
- Druhý trimestr (14. týden těhotenství až 27. týden těhotenství)
- Třetí trimestr (28. týden těhotenství až 40. a více týden těhotenství)
- Zdravotní péče, prohlídky a vyšetření v těhotenství
- Změny v těle matky během těhotenství
- Komplikace v těhotenství
- Jak si těhotenství užít?
Související články
Vybraná anketa
Souhlasíte s omezením odkladů za současného zrušení přípravných tříd?
27 %
19 hlasů
68 %
48 hlasů
6 %
4 hlasy
Celkem hlasovalo 71 unikátních návštěvníků
Zvolte si svůj týden těhotenství

- Před těhotenstvím
- 1. týden
- 2. týden
- 3. týden
- 4. týden
- 5. týden
- 6. týden
- 7. týden
- 8. týden
- 9. týden
- 10. týden
- 11. týden
- 12. týden
- 13. týden
- 14. týden
- 15. týden
- 16. týden
- 17. týden
- 18. týden
- 19. týden
- 20. týden
- 21. týden
- 22. týden
- 23. týden
- 24. týden
- 25. týden
- 26. týden
- 27. týden
- 28. týden
- 29. týden
- 30. týden
- 31. týden
- 32. týden
- 33. týden
- 34. týden
- 35. týden
- 36. týden
- 37. týden
- 38. týden
- 39. týden
- 40. týden
- Po 40. týdnu
Aktuální soutěže
Aktuální testování
Těhotenská kalkulačka
Vypočtěte si v naší těhotenské kalkulačce, kdy Vás čekají ultrazvuky, kdy obdržíte těhotenskou průkazku, kdy se podrobíte triple testu, kdy se vyšetřuje streptokok, kdy se provádí amniocentéza, kdy byste si měla nachystat věci do porodnice, kdy nastupujete mateřskou dovolenou.
TĚHOTENSKÉ E‑MAILY
Zaregistrujte se na Babyonline.cz, uveďte termín porodu a každý týden vám automaticky přijde e-mail s informacemi o vašem těhotenství týden po týdnu a vývoji miminka!